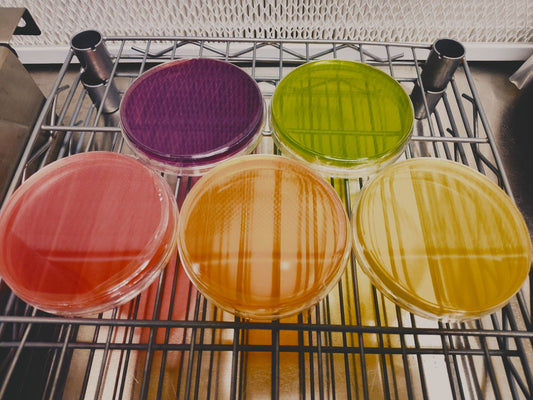

-
"Surprise Me" Mushroom Grow Kit
Regular price $30.00Regular priceUnit price per -
Agar Plates
Regular price $5.00Regular priceUnit price per -
Baltispore 16oz Refillable Growler Bottle (Unfilled)
Regular price $9.99Regular priceUnit price per -
BaltiSpore Deluxe Two-Toned Shopping Bag
Regular price $25.00Regular priceUnit price per -
BaltiSpore Embroidered Logo Organic ribbed beanie
Regular price $25.00Regular priceUnit price per -
BaltiSpore Embroidered Logo Oversized faded t-shirt
Regular price $45.00Regular priceUnit price per -
BaltiSpore Gift Cards
Regular price From $20.00Regular priceUnit price per -
BaltiSpore Sample Pack
Regular price $57.00Regular priceUnit price per -
BaltiSpore Sweatpants
Regular price $40.00Regular priceUnit price per -
BaltiSpore Vintage Corduroy Cap
Regular price $27.00Regular priceUnit price per -
Bear Bones - Turkey Tail Infused Dog Treats
Regular price $19.95Regular priceUnit price per -
Blank Liquid Culture Expansion Kit
Regular price $20.00Regular priceUnit price per -
Blue Oyster “Ready-To-Fruit” Mushroom Grow Kit
Regular price $30.00Regular priceUnit price per -
Bury & Grow Block
Regular price $18.00Regular priceUnit price per -
Chaga Mushroom Tincture
Regular price $45.00Regular priceUnit price per -
Chestnut “Ready-To-Fruit” Mushroom Grow Kit
Regular price $30.00Regular priceUnit price per -
Cold Pack for Summer Orders
Regular price $20.00Regular priceUnit price per -
Colonized Grain Spawn (15lbs)
Regular price $75.00Regular priceUnit price per -
Cordyceps Mushroom Tincture
Regular price $45.00Regular priceUnit price per -

 Sold out
Sold out -
Five Panel BaltiSpore Crown Cap
Regular price $30.00Regular priceUnit price per -
Full Spectrum Tincture Set
Regular price $215.00Regular priceUnit price per -
Full Spectrum Tincture Set
Regular price $215.00Regular priceUnit price per -
Full Spectrum Tincture Set + Growler Bottle
Regular price $223.00Regular priceUnit price per